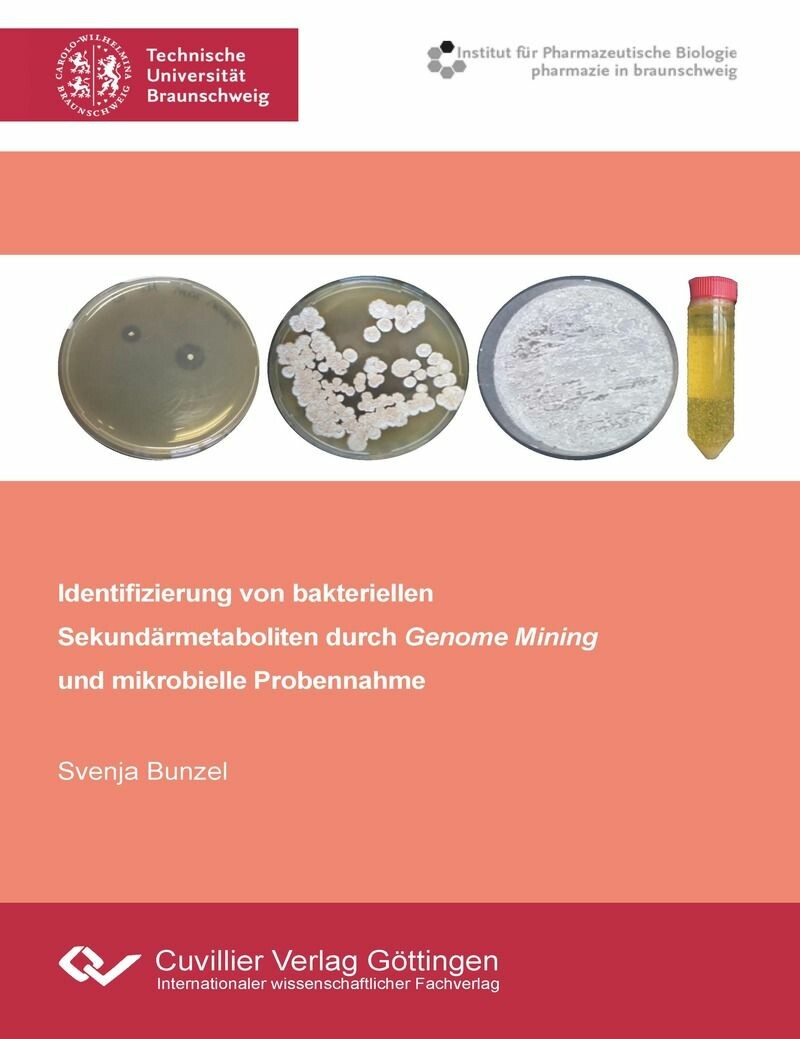
Identifizierung von bakteriellen Sekundärmetaboliten durch Genome Mining und mikrobielle Probennahme

Identifizierung von bakteriellen Sekundärmetaboliten durch Genome Mining und mikrobielle Probennahme
| Auflage | 1. Auflage, 2022 |
| Verlag | Cuvillier Verlag |
| ISBN | 9783736967106 |
Sofort zum Download (Download: PDF)
Produktbeschreibung
Aufgrund der steigenden Vorkommen resistenter bzw. multiresistenter Pathogene ist es notwendig neue Therapeutika mit antibiotischer Aktivität zu entdecken. Ein großes Potential besitzen die Bodenbakterien als Bildner neuer Antibiotika, allen voran die Gram-positiven Streptomyceten. Sie bilden u.a. Nicht-ribosomale Peptide (NRP). Um neuartige NRP zu entdecken, kann ein Genome Mining Ansatz verfolgt werden.
In dieser Arbeit wurde ein neuartiges biosynthetisches Gencluster, welches für 2 Nicht-ribosomale Peptidsynthetasen codiert, identifiziert. Da in dem Cluster mehrere clusterspezifische Regulatoren und Gene für Selbstresistenzen enthalten sind, wurde angenommen, dass das NRP eine antibiotische Wirksamkeit besitzt. Ziel der Arbeit ist es das gebildete NRP zu identifizieren und isolieren.